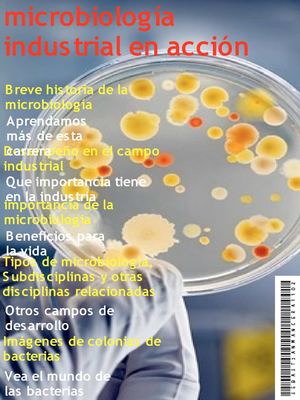
microbiología industrial en acción

5/4/13
Haga clic para modificar el estilo de
subtítulo del patrón
microbiología
industrial en acción
Breve historia de la
microbiología
importancia de la
microbiología
Tipos de microbiología,
S ubdisciplinas y otras
disciplinas relacionadas
Desempeño en el...
More
5/4/13
Haga clic para modificar el estilo de
subtítulo del patrón
microbiología
industrial en acción
Breve historia de la
microbiología
importancia de la
microbiología
Tipos de microbiología,
S ubdisciplinas y otras
disciplinas relacionadas
Desempeño en el campo
industrial
Imágenes de colonias de
bacterias
Aprendamos
más de esta
carrera
Vea el mundo de
las bacterias
Otros campos de
desarrollo
Que importancia tiene
en la industria
Beneficios para
la vida
Less